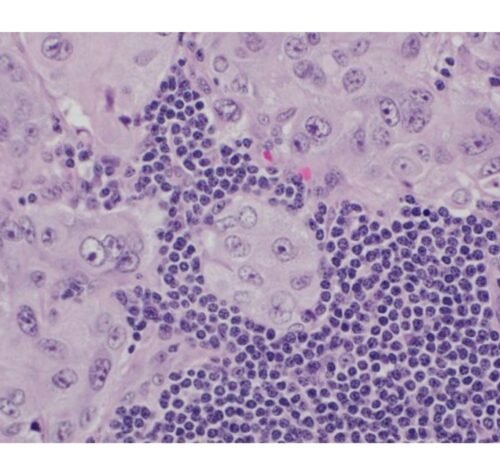

Netanjahu chwali „Bold Vision” Trumpa dla Gazy na spotkaniu Rubio
Premier Izraela powiedział, że pracuje nad uczynieniem planu Prezydenta USA Donalda Trumpa, aby usunąć i zresetować populację Gazy „rzeczywistością”.Benjamin Netanyahu powiedział, że współpracuje.